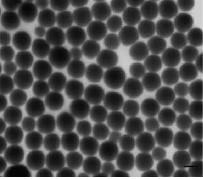
TEM image of uniform, monodisperse chemically synthesized selenium nanoparticles

Selenium Nanoparticles Applications
Read more about
- Enhancing Health and Technology with Monodisperse Selenium Nanoparticles
- Utilizing Selenium Nanoparticle for COVID-19 Detection
- Nano-Sized Particles for Enhanced Nutritional Benefits in Animal Feed and Human Food Supplements
- Selenium Nanoparticles as Antimicrobial Coating for Medical Device
- Mechanisms and Applications of Selenium Nanoparticles for Cancer Therapy
- Potential of Selenium in Solar Cells
- Selenium Nanoparticles for Drug Delivery and Enhanced Skin Penetration
- Selenium Nanotechnology in Agriculture: Benefits of Nanoparticle Fertilizers for Crop Production and Soil Health
- The Relationship Between Selenium and Diabetes: Evidence and Implications
- Role of Selenium as an Antioxidant in Inflammatory Diseases: Implications for Diabetes, Celiac, and HIV
- Se Nanoparticles as Antibacterial Agents: Properties and Mechanisms of Action
- Understanding Mask Efficacy Against COVID-19: Novel Testing Methods Using Selenium Nanoparticles
- Related Products
Enhancing Health and Technology with Monodisperse Selenium Nanoparticles
Selenium is an essential trace element, vital for both human and livestock nutrition. It is a necessary dietary constituent of at least 25 human selenoproteins and enzymes containing selenocysteine. Due to its many health benefits, selenium is a common additive to animal feeds and nutritional products. Additionally, as selenium is a semiconductor and photoelectrically active, it has more advanced applications such as xerography and solar cell assembly. Selenium rarely occurs in its elemental state and has typically been observed in its organic (selenomethionine, selenocysteine) or inorganic (selenate, selenide, selenite) forms.
The development of uniform, monodisperse, nanometer-sized selenium particles have gained commercial interest, as nanoparticles often display unique electrical, optical, magnetic, and chemical properties in comparison to their bulk counterpart materials. The application of selenium nanoparticles (SeNPs) are of particular interest as they have been shown to enhance selenium’s biological and photoelectric properties. Furthermore, SeNPs are biocompatible and non-toxic, and exhibit low cytotoxicity compared to their counterparts, selenite (SeO32-) and selenate (SeO42-).

Figure 1.Monodisperse selenium colloids: Photographic images of six particle diameters ranging from 20 to 240 nm. The particles are shown from left to right, with the smallest diameter on the left and the largest on the right (20±6,71±9, 102±10, 146±23, 183±33, and 240±32 nm, respectively).
Figure 2.TEM micrograph of monodisperse selenium nanoparticles, highlighting the uniform size and shape, with little variation between particles. [Lin et al Materials Chemistry and Physics 92 (2005) 591-594].
Utilizing Selenium Nanoparticle for COVID-19 Detection
Nanoparticles (NPs) have been frequently used in many medical applications including biosensing, drug delivery, imaging, and antimicrobial treatment. Due to their high surface area and ultrasmall size, NPs have been applied in reverse-transcriptase polymerase chain reaction (RT-PCR) methods, among other virus detection methods, including enzyme-linked immunosorbent assay (ELISA) and reverse transcription loop-mediated isothermal amplification (RT-LAMP). Severe acute respiratory syndrome coronavirus 2 (SARS-CoV-2) is an enveloped virus with particle-like characteristics and a diameter of 60-140 nm (Figure 3). It may be regarded as a functional core-shell nanoparticle (NP) and can interact with diverse materials in its vicinity, remaining attached for variable times while preserving its bioactivity. It has been observed that synthetic NPs can closely mimic the virus and interact strongly with its proteins due to their morphological similarities.

Figure 3.Cartoon representation of the SARS-CoV-2 structure.
A study by Wang et al. discussed the development of a point-of-care SeNP-based test for the combined detection of anti-SARS-CoV-2 IgM and IgG in human serum and blood. The test involved a lateral flow immunoassay kit based on a selenium nanoparticle-modified SARS-CoV-2 nucleoprotein, which detects anti-SARS-CoV-2 IgM and anti-SARS-CoV-2 IgG in human serum, producing visually detectable results within 10 minutes (see Figure 4 for illustration of testing kit).
SeNPs may thus be used as a labeling probe in lateral chromatography experiments. Such NPs have a surface plasmon effect and a small-size effect, and may be used to label proteins or nucleic acids. A positive result may be represented by the presence of visible orange lines as SeNPs are orange in color. SeNPs are advantageous as they display higher levels of sensitivity and are more cost-effective than other probe types.

Figure 4.Components and Interpretation of the SARS-CoV-2 Antibody Immunoassay Test Strip. (a) The diagram depicts the different components of the test strip; (b) The visual assessment guidelines help the user interpret the test strip results by identifying the control line and test line (C and T, respectively) and the presence or absence of IgM and IgG antibodies. [Wang et al. Lab Chip, 2020, 20, 4255]
Nano-Sized Particles for Enhanced Nutritional Benefits in Animal Feed and Human Food Supplements
Nano-sized particles may offer nutritional benefits, such as enhanced absorption, bioavailability, antimicrobial activity, and excretion of the nanomaterials. The supplementation of animal nutrition products with SeNPs has shown highly promising outcomes when added to monogastric, ruminant, and aquatic feeds (see Figure 5. for applications of SeNPS in animal feeds). Nanoparticle delivery of minerals is effective in improving feed conversion ratio, promoting growth and development of muscle cells, improving the gut microbial environment, treating common parasitic diseases, such as coccidiosis, and reducing mortality in poultry. Traditionally, selenium is added to animal feeds in either its inorganic (selenite) or organic (seleno-methionine) form. However, the use of selenium in its nanoparticle form in animal feed may be an attractive alternative, as it does not need to be metabolized before being incorporated into selenoproteins, and is thus more bioavailable than inorganic selenium. At present, there is a void of human SeNP supplementation trials and commercial products. However, this is an area of highly promising research.

Figure 5.Applications of selenium nanoparticles in animal feeds.
Selenium Nanoparticles as Antimicrobial Coating for medical device
Nanoparticles have been widely investigated for various medical applications because of their high surface-to-volume ratios and their smaller size when compared with conventional micron-sized particles. Their high surface area provides more sites for interacting with biological entities and functionalization with other bioactive molecules, such as anticancer and antibacterial drugs. Nanostructured selenium increases the surface area available to interact with and kill bacteria in addition to changing the surface morphology to ultimately inhibit the attachment of bacteria. Additionally, SeNPs have shown a sevenfold lower acute toxicity than sodium selenite in mice showing less prooxidative effects.
Biofilms are a common cause of persistent infections on medical devices as they are easy to form and difficult to treat. SeNPs may be coated on the surface of medical devices (such as those used for catheters, orthopedic prostheses, contact lenses, prosthetic heart valves, etc.) to prevent biofilm formation. A study by Wang et al. demonstrated that polycarbonate medical devices coated with SeNPs strongly inhibited the growth of S. aureus bacteria on the surface after 24 and 72 hours by 91% and 73% respectively when compared with uncoated polycarbonate surfaces. Importantly, this was achieved without using antibiotics, rather an element natural to the human body. Figure 6 illustrates the decrease in S. aureus densities with increasing selenium concentration on the surface of polycarbonate.

Figure 6.Results of a study on the antibacterial properties of selenium-coated polycarbonate films. The figure presents the densities of S. aureus bacteria cultured on various amounts of selenium for different time periods. The data suggests that selenium-coated polycarbonate surfaces can effectively inhibit bacterial growth, which has potential applications in food packaging and medical devices. [Wang et al. Lab Chip, 2020, 20, 4255]
Mechanisms and Applications of Selenium Nanoparticles for cancer Therapy
Selenium supplementation has been suggested as a powerful anti-carcinogenic therapy. Large-scale, double-blind, randomized human intervention trials have shown that selenium supplementation of 200 µg/day can lead to a non-significant reduction in all-cause mortality and significant reductions in total cancer mortality, and incidences of lung, colorectal, and prostate cancers. Although human intervention trials specifically using SeNPs are scarce, in vitro studies have observed that SeNPs functionalized with folic acid can induce apoptosis in cancer cell lines (breast cancer cell line (MCF-7). Additionally, SeNPs have been shown to cause cell shrinking and damage to prostate cancer cells during culture by causing cytotoxic activity. Due to their small size and large surface area, supplemental SeNPs may increase selenium bioavailability and anticarcinogenic effects.
The mechanism of action of chemoprotective effects of selenium is not fully known. However, several hypotheses have been proposed to explain selenium’s antitumorigenic activities. These may include protection against oxidative damage (via its function as a component of the antioxidant enzyme glutathione peroxidase), alterations in carcinogen metabolism, effects on the endocrine and immune systems, production of cytotoxic selenium metabolites, inhibition of protein synthesis, inhibition of specific enzymes; and stimulation of apoptosis. Figure 7 explores the possible chemo-preventive roles of selenium.

Figure 7.Role of Se in Cancer Prevention and Treatment. Panel (A) represents various factors leading to increased risks of cancer and the protective effect of selenium against them. Panel (B) illustrates the schematic model of apoptosis of cancerous cells in the presence of selenium nanoparticles, which promote cancer cell death. [Maiyo et al Nanomedicine 2017 Vol 12 No 9]
Potential of Selenium in Solar Cells
Selenium has several key features which make it a desirable solar cell component, such as high sensitivity to light, ease of processing, and stability. This element shows a high absorption coefficient and mobility, making it an attractive absorber for high bandgap thin-film solar cells. Furthermore, the simplicity of a single element absorber (which significantly simplifies the deposition process) and intrinsic environmental stability enable the utilization of selenium in extremely cheap and scalable solar cells. Selenium-based solar cells have advantageous features over silicon and other emerging photovoltaic materials. They can be processed at significantly lower temperatures (below 200 °C) than silicon or CdTe processing temperatures. Selenium solar cells also show inherent stability to ambient conditions (e.g. humidity and oxygen). Furthermore, selenium is a p-type semiconductor, and studies have shown that that selenium has bipolar transport properties and can work as both a great transporter as well as a light absorber. A study by Pejjai et al. successfully incorporated tin monoselenide (SnSe) NPs into thin-film solar cells which showed an efficiency of 0.43%. Figure 8 represents a schematic and features of SnSe NP solar cells.

Figure 8.SnSe NPs Solar Cell: (a) Schematic of heterojunction solar cell (b), Current-density vs. voltage (J-V) characteristics, (c) and SEM image of the SnSe absorber layer detailing the morphology and thickness of the SnSe NPs absorber layer. [Pejjai et al. J Mater Sci: Mater Electron 27, 5491–5508 (2016).]
Selenium Nanoparticles for Drug Delivery and Enhanced Skin Penetration
The widespread use of nanotechnology is escalating in cosmeceuticals and nano-cosmeceuticals used for skin, hair, nail, lip-care, and conditions like wrinkles, photoaging, hyperpigmentation, dandruff, and haircare damage. Due to their large surface area, novel nanocarriers, such as SeNPs, have advantages of enhanced skin penetration, controlled and sustained drug release, higher stability, solubility, and enhanced bioavailability as well as site-specific targeting and high entrapment efficiency (see Figure 9 for advantages of nano-cosmeceuticals).
Selenoproteins play a key role in antioxidant defense and in maintaining a reduced cellular environment. UV radiation can include reactive oxygen species (ROS) which are key mediators of oxidative skin damage. Repeated exposure to UV-A and UV-B can increase the risk of sunburn. Furthermore, oxidative stress (which is mainly driven by UV-A radiations) can result in premature aging, tanning, and skin cancer. Selenium has been incorporated into sunscreen products in the form of nanoparticles as it has reduced toxicity in comparison to its more commonly used counterparts. The antioxidant activity of selenium enhances the activity of redox enzymes involved in free radical scavenging offering an effective alternative for the treatment of sunburn complications. The antioxidant effects of topical application of SeNPs may reduce oxidative stress by eliminating ROS and exhibiting an acidic pH (in the range of 4.2-5.6), which aids in the prevention of pathogenic bacterial colonization, regulation of enzyme activity, and maintenance of a moisture-rich environment.

Figure 9.Positive aspects of nanoparticles in cosmetics for skincare applications.
Selenium Nanotechnology in Agriculture: Benefits of Nanoparticle Fertilizers for Crop Production and Soil Health
The selenium content of soils varies greatly throughout the world and may range from 0.005 to 1200 µg g-1 although it is typically between 0.1 and 10 µg g-1. A person’s dietary selenium intake and thus plasma selenium levels are highly dependent on the soil selenium content in the food they eat. The normalization of selenium soil concentration may be achieved via the use of selenium-containing fertilizers. Nanoscale selenium is of great interest as an additive to fertilizers. In comparison to organic and inorganic selenium compounds, SeNPs do not dissolve in water and aqueous solutions and are not leached from the soil quickly. Se may be supplied from the soil to plants via nanoparticle surface gradual oxidation and oxide release to the soil solution.
Studies have noted that soil fertilized with SeNPs leads to higher yields of fruit, rice, and tea leaves with a higher selenium content in the fruit. Furthermore, SeNPs added to fertilizer improved the growth cycle of blueberries which were of higher quality and had a longer storage period (see Figure 10 for the impact of varying SeNP fertilization concentrations on a radish plant). SeNPs have been shown to enhance the disease-suppressing and antifungal abilities of plants. In addition, the large surface area and small size of the nanomaterials in nano-fertilizers allow for enhanced interaction and efficient uptake of selenium for crop fertilization. This increase in uptake efficacy could lead to significant economic and environmental benefits.

Figure 10.Radish seedling growth in response to SeNPs fertilization. Radish seedlings grown in (a) unfertilized soil and in soil fertilized with (b) 1, (c) 5, (d) 10, and (e) 25 µg g-1 SeNPs. The highest plant growth rate was observed in SeNPs concentrations of 5 and 10 μg, as shown in images (c) and (d), respectively.
The Relationship Between Selenium and Diabetes: Evidence and Implications
Although evidence of the effect of selenium on diabetes is somewhat lacking, studies have observed that diabetic patients have lower selenium status compared with controls. The prevalence of diabetes tends to be greater in men with low plasma selenium levels. Furthermore, a study noted that pregnant women with gestational diabetes had lower serum plasma levels compared to controls and significant negative correlations were found between serum selenium levels and CRP, total- and LDL-cholesterol levels. The antioxidant power of selenium may have a neutralizing effect against oxidative stress, which plays a major role in the pathogenesis of diabetes. Moreover, it has been hypothesized that selenium may influence glucose metabolism. Selenium supplementation has been shown to reduce the expression of inflammatory proteins, such as interleukins and tumor necrosis factors in diabetic patients. The toxicity range for selenium is however very narrow and caution must be exerted to ensure beneficial therapeutic effects. Other research has suggested that the prevalence of diabetes is greater in those with a high plasma selenium status. At present, data available on the levels of plasma selenium and diabetes risk may be represented by a u-shaped graph (Figure 11). This implies that both low and high selenium intakes could influence the risk of diabetes and other clinical mortalities. Hence, although observational evidence suggests low selenium status may increase one’s risk of developing diabetes, further research is needed to explore a safe supplemental selenium intake to achieve beneficial therapeutic effects.

Figure 11.U-shaped graph illustrating the risk of health complications versus selenium status.
Role of Selenium as an Antioxidant in Inflammatory Diseases: Implications for Diabetes, Celiac, and HIV
Selenium is a major antioxidant element, acting via enzymes that catalyze redox reactions. These selenoproteins play a pivotal role in the antioxidant defense system of the cell. There is strong evidence to suggest that selenium may have an impact on the course and outcome of many inflammatory diseases (diabetes, celiac, HIV). Current data indicates that viral-, bacterial-, or stress-induced inflammation may be variably influenced by selenium availability.
Decreased serum selenium levels have been observed in acute and chronic inflammatory states with high CRP values. Low selenium levels have also been noted in severe inflammatory response syndrome, which is marked by increased production of reactive oxygen species (ROS) by activated macrophages, induction of oxidative damage, and tissue injury. The nuclear factor kappa-B (NF-KB) signaling pathway has been associated with enhanced inflammatory response and its activation has been significantly correlated with interleukin-6 and TNF-alpha production. Selenium is hypothesized to inhibit the activation of NF-KB by modulating gene expression. Supplementation with selenium in chronic inflammation restores the depleted hepatic and serum selenium levels by increasing selenoprotein biosynthesis. This effect leads to suppressed CRP production and thus attenuates the inflammatory response. Figure 12 illustrates the relationship between selenoenzymes and the inflammatory response. Although there is currently a scarcity of published human trials investigating the anti-inflammatory effects of SeNP supplementation it is a promising area for future research, as nanosized particles may have increased bioavailability than their larger counterparts and thus enhanced therapeutic effects.

Figure 12.Representation of the mechanisms of selenium supplementation on inflammation. Selenium supplementation can inhibit NF-KB binding to promoter genes, reduce cytokine release, and suppress CRP synthesis. Plasma selenium levels affect the activity of selenoenzymes, which inhibit the activation of protein kinases and the phosphorylation of IκBα.
Se Nanoparticles as Antibacterial Agents: Properties and Mechanisms of Action
The high surface-to-volume ratio, target-specificity, high biocompatibility, and high reactivity properties of SeNPs may make them successful antibacterial agents. The nanoparticles may interact with cellular components such as ribosomes, DNA, and RNA and cause alterations in this process. It is assumed that the nanoparticles permeate through the cell membrane via endocytosis, then the cytosol, and damage the genetic components of the bacterial cells.
SeNPs have been shown to act as effective antimicrobial agents against gram-positive bacteria. A Glantreo Ltd. trial noted that when an aqueous SeNP solution was coated to a polyethylene coverslip, it was effective at reducing the number of colony-forming units/ml of MRSA bacteria by over 98% within a 2-hour incubation period. As MRSA is known to be antibiotic-resistant, the exploitation of SeNPs as an antimicrobial agent for biomedical applications may thus be highly encouraging.
The antibacterial activity of SeNPs was shown by Huang and colleagues to be highly size-dependent. SeNPs measuring approx. 80 nm showed the maximal growth inhibition and killing effect of MRSA. It was concluded that the SeNPs displayed size-dependent, multi-modal mechanisms of action, including depleting internal ATP (Figure 13), inducing ROS production, and disrupting membrane potential.

Figure 13.ATP level of S. aureus with different sizes of SeNPs. Stevanovic et al (Front. Bioeng. Biotechnol. 8:624621.)
The antimicrobial effects of SeNPs have numerous industrial and medical applications. Khiralla et al. noted that biogenic SeNPs (MIC90 25 µg/mL) displayed antimicrobial effects against 6 foodborne pathogens: B. cereus, E. faecalis, S aureus, E. coli 0157:H7, S. Typhimurium, and S. Enteritidis (Figure 14).

Figure 14.Antimicrobial effect of (0, 5, 10, 15, 20, 25, 30, 35 and 40 µg/mL) SeNPs against 3 gram-negative food borne pathogens. The growth of the tested strains was measured as optical density at 595 nm (OD595). 40 µg/mL SeO2/mL was tested as an additional control. A column with different small letters indicates the significant effect (p < 0.05) within each group. Asterisked column (*) indicates a significant difference (p < 0.05) between strains at the same SeNPs concentration. (Khiralla et al. LWT-Food Science and Technology 63 [1001–7])
Understanding Mask Efficacy Against COVID-19: Novel Testing Methods Using Selenium Nanoparticles
The current COVID-19 pandemic is caused by the novel coronavirus, SARS-CoV-2, which is transmitted largely by the respiratory route (vide infra). Recent studies suggest that wearing facemasks reduces the spread of COVID-19 on a population level and consequently blunts the growth of the epidemic curve.
SARS-CoV-2 has a size ranging from 60 to 140 nm, smaller in size than bacteria, dust, and pollen. Therefore, masks made of materials with larger pore sizes such as cotton and synthetic fabric, will not be able to effectively filter these viruses or tiny virus-laden droplets, as compared with those made of materials with much smaller pore sizes. Additionally, prior research shows that cloth materials offer limited protection from particles in the size regime of SARS-CoV-2.
When particles interact with a filter fiber, it is generally accepted that they are “collected” by fiber and retained through van Der Waals forces. For small particles, Brownian motion increases the probability a particle will interact with a filter fiber. At larger sizes, particles can be intercepted by a fiber when they are within one particle radius.
Determining mask efficacy is a complex topic that is still an active field. It has been proposed that by passing an aerosol solution containing nanoparticles of a similar size range to SARs-CoV-2 through a mask material and observing the level of solution retained, one may infer the efficacy of the mask material in reducing the spread of virus-laden droplets.
Selenium nanoparticles may be synthesized to form nanoparticles within the size range characteristic of SARS-CoV-2 (60 – 140 nm). As these spherical, monodisperse nanoparticles form a characteristic orange-red color in their aqueous form (Figure 15).

Figure 15.Photograph of aqueous dispersions of selenium nanoparticle ranging in color from orange to red.
It may be suggested that by directing a nebulized aerosol solution of colored nanoparticles towards a mask material and observing the level of solution captured by the mask and subsequent level of uncaptured particles (colored aerosol passing through the mask material), one may thus determine the effectiveness of the material under investigation at inhibiting the spread of SARS-CoV-2. Figure. 16 illustrates a design for evaluating the viral efficacy of mask materials.

Figure 16.Drawing of a design using the six-stage Andersen sampler to evaluate the efficacy of mask materials against bacteria and virus.
To continue reading please sign in or create an account.
Don't Have An Account?